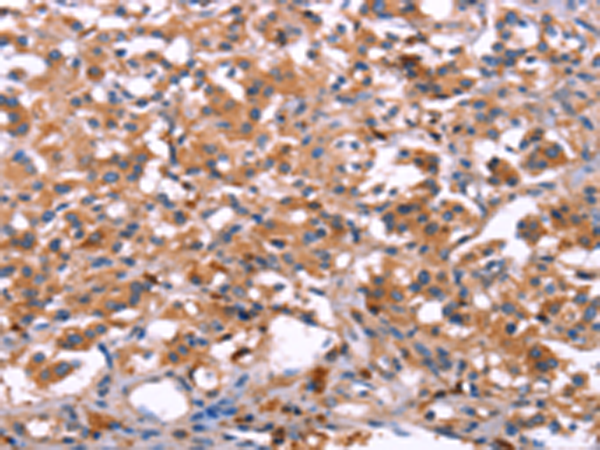
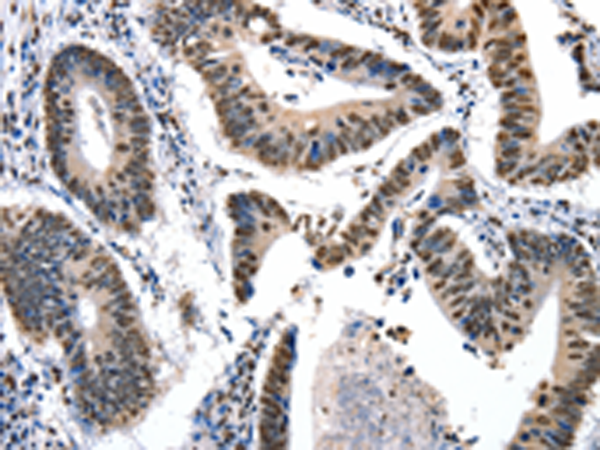

-
分类: 科研抗体货号: P07398别名: ILT4, LIR2, CD85D, LIR-2, MIR10, LILRA6, MIR-10应用: IHC反应种属: Human
-
分类: 科研抗体货号: P07380别名: HMP, P87, P89, PIG4, PIG52, MINOS2, P87/89应用: WB,IHC反应种属: Human, Mouse
-
分类: 科研抗体货号: P07412别名: LAMA3; CMD1JJ; LAMA4*-1应用: IHC反应种属: Human
-
分类: 科研抗体货号: P07397别名: ILT2; LIR1; MIR7; CD85J; ILT-2; LIR-1; MIR-7应用: IHC反应种属: Human
-
分类: 科研抗体货号: P07406别名: KKLF应用: IHC反应种属: Human, Mouse
-
分类: 科研抗体货号: P07411别名: ML8, KU70, TLAA, CTC75, CTCBF, G22P1应用: IHC反应种属: Human, Mouse
-
分类: 科研抗体货号: P07396别名: IRAK-2应用: WB,IHC反应种属: Human
-
分类: 科研抗体货号: P07405别名: FKLF; FKLF1; MODY7; TIEG2; Tieg3应用: WB反应种属: Human, Mouse
-
分类: 科研抗体货号: P07410别名: hK7, SCCE, PRSS6应用: WB,IHC反应种属: Human, Mouse
-
分类: 科研抗体货号: P07395别名: AIP70; SIMPL应用: WB,IHC反应种属: Human, Mouse

鄂公网安备42018502007531号
鄂公网安备42018502007531号

